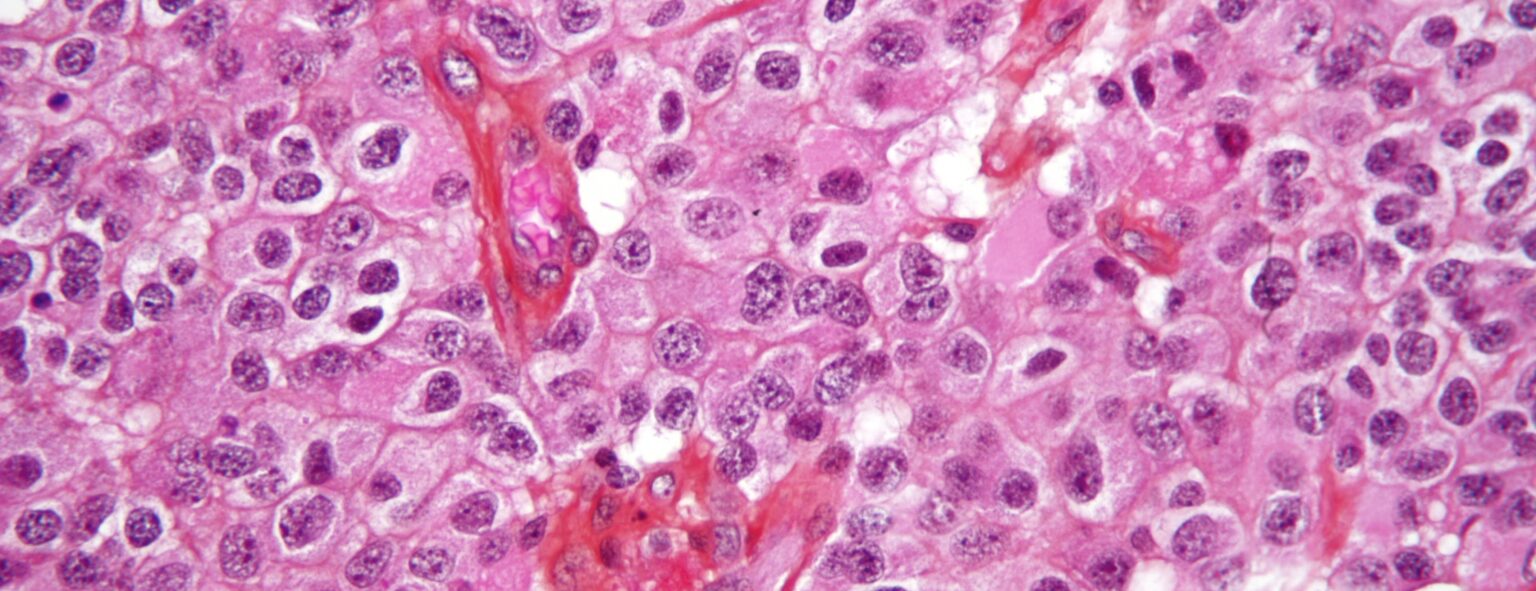
Oligodendroglioma1 high mag1 e1414718034748 أورام المخ المختلفة تنبع من ذات الخلايا مجلة نقطة العلمية

يبدو أن هناك بحثاً جديداً قام به باحثون في جامعة أوبسالا أظهر شيئاً يمكن له أن يغير كل الذي اعتدنا أن ندرسه بشأن الـGlioma -وهي أحد أورام المخ الخطيرة -فقد قالوا أن الأنواع المختلفة التي نعرفها ليست من خلايا مختلفة وإنما قد تنشأ من خلية واحدة فقط، فالخلية الواحدة تستطيع أن تنتج أنواعاً مختلفة من الأورام.
فما الفرق الذي قد ينتج عن معرفة هذا؟
يمثل هذا الاكتشاف مدخلاً لفهم كيفية نشوء هذه الأورام كما أنه يقودنا لمعرفة علاجات لورم الـ Glioma أكثر فعالية وأكثر تحديداً.
الـ glioma هي ورم مكون من الـ Glial cellsالخلايا الصمغية (باليونانية كلمة Glia تعني Glue أو صمغ)، سميت كذلك لأنه من وظائفها إحاطة الخلايا العصبية وإبقاؤها في مكانها.
أكثر أنواع هذا السرطان الخطير شيوعاً هو سرطان الخلايا النّجمية astrocytoma ، وهي التي لها زوائد تجعلها تشبه النجمة في شكلها، أيضاً لدينا سرطان الخلايا قليلة الغصون oligodendroglioma، وكانوا يعتقدون أن السرطان الأول ينشأ من الخلايا النجمية لأنه يشبهها وأن الثاني ينشأ من الخلايا قليلة الغصون لأنه يشبهها كذلك، كما إن تطور المرض في السرطان النجمي أسوأ من الآخر، لذا بقي الأطباء يعتقدون أن لكل منهما نوع وتشخيص منفصل عن الآخر.
إذا كان لديك شجرتان كلاً منهما تنتج ثماراً مختلفة في الشكل والطعم فإنك تستنتج بالطبع أن لهما بذوراً مختلفة، لهذا اعتقد العلماء في البداية أن سرطان الخلايا النجمية نابع من الخلايا النجمية وسرطان الخلايا قليلة الغصون نابع منها، لكن في هذا البحث الذي عمل فيه الفريق على هذين السرطانين في الفئران والتي تشابه سرطانات الإنسان جداً وجدوا أن خلية واحدة تسمى oligodendrocyte precursor يمكن لها أن تنتج النوعين.
واكتشفوا أن اختلاف السرطانين الشهيرين عن بعضهما ليس بسبب اختلاف البذور أو خلايا المنشأ، وإنما بسبب اختلاف الخلل الجيني، أي أنهما وجهان لعملة واحدة فقط، يختلف الاتجاه الذي تقلبه اليد التي تمسك بها حسب نوع الخلل الجيني، حتى مع اختلافهما وجد العلماء الكثير من الشبه بين الانحرافات الجينية لكليهما، أي أنهما لم يكونا مختلفين بالدرجة التي تصورناها في البداية، وهذاسوف يصنع فارقاً بالتأكيد في فهمهم وفي علاجهم أيضاً منذ الآن فصاعداً.